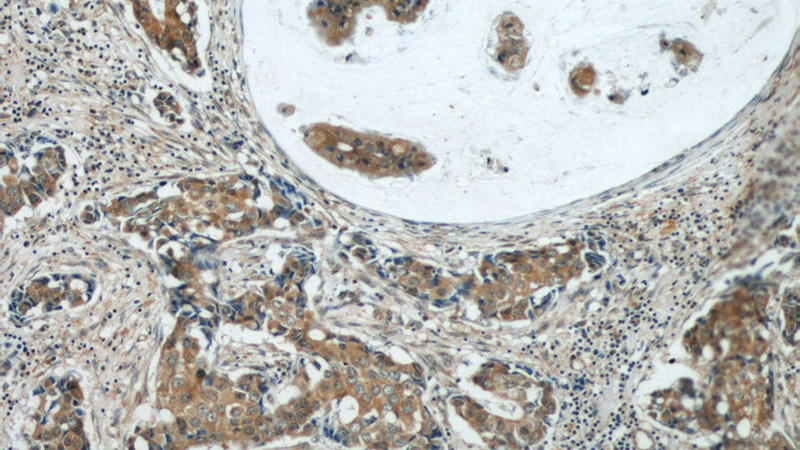
Immunohistochemical of paraffin-embedded human breast cancer using Catalog No:107899(AEG-1 antibody) at dilution of 1:50 (under 10x lens)
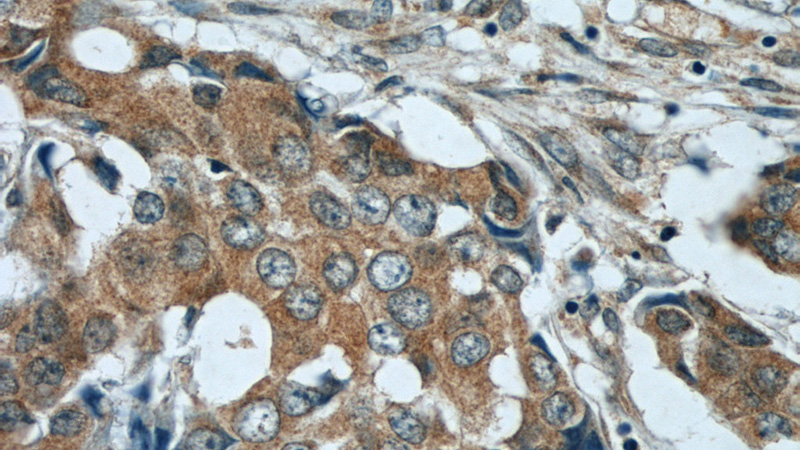
Immunohistochemical of paraffin-embedded human breast cancer using Catalog No:107899(AEG-1 antibody) at dilution of 1:50 (under 40x lens)

-
Product Name
AEG-1/MTDH-Specific antibody
- Documents
-
Description
AEG-1/MTDH-Specific Rabbit Polyclonal antibody. Positive IP detected in MCF-7 cells. Positive WB detected in MCF7 cells, A375 cells, A549 cells, DU 145 cells, HeLa cells, HepG2 cells, PC-3 cells, RAW 264.7 cells. Positive IHC detected in human prostate cancer tissue, human breast cancer tissue, human liver cancer tissue, human stomach cancer tissue, mouse brain tissue. Positive IF detected in MCF-7 cells. Observed molecular weight by Western-blot: 65-70 kDa
-
Tested applications
ELISA, WB, IHC, IF, IP
-
Species reactivity
Human,Mouse,Rat; other species not tested.
-
Alternative names
3D3 antibody; 3D3/LYRIC antibody; AEG 1 antibody; AEG1 antibody; LYRIC antibody; LYRIC/3D3 antibody; metadherin antibody; Metastasis adhesion protein antibody; MTDH antibody; Protein LYRIC antibody
- Immunogen
-
Isotype
Rabbit IgG
-
Preparation
This antibody was obtained by immunization of AEG-1/MTDH-Specific recombinant protein (Accession Number: NM_178812). Purification method: Antigen affinity purified.
-
Clonality
Polyclonal
-
Formulation
PBS with 0.02% sodium azide and 50% glycerol pH 7.3.
-
Storage instructions
Store at -20℃. DO NOT ALIQUOT
-
Applications
Recommended Dilution:
WB: 1:500-1:5000
IP: 1:500-1:5000
IHC: 1:20-1:200
IF: 1:20-1:200
-
Validations

MCF7 cells were subjected to SDS PAGE followed by western blot with Catalog No:107899(AEG-1 antibody) at dilution of 1:1000

WB result of AEG-1/MTDH antibody (Catalog No:107899, 1:2000) with si-Control and si-MTDH transfected A549 cells.
Immunohistochemical of paraffin-embedded human breast cancer using Catalog No:107899(AEG-1 antibody) at dilution of 1:50 (under 10x lens)
Immunohistochemical of paraffin-embedded human breast cancer using Catalog No:107899(AEG-1 antibody) at dilution of 1:50 (under 40x lens)

Immunohistochemical of paraffin-embedded human prostate cancer using Catalog No:107899(AEG-1 antibody) at dilution of 1:100 (under 10x lens)

Immunohistochemical of paraffin-embedded human prostate cancer using Catalog No:107899(AEG-1 antibody) at dilution of 1:100 (under 40x lens)

Immunofluorescent analysis of MCF-7 cells, using MTDH antibody Catalog No:107899 at 1:50 dilution and Rhodamine-labeled goat anti-rabbit IgG (red). Blue pseudocolor = DAPI (fluorescent DNA dye).

IP Result of anti-AEG-1 (IP:Catalog No:107899, 3ug; Detection:Catalog No:107899 1:1000) with MCF-7 cells lysate 3250ug.
-
Background
MTDH, also known as AEG-1, is a single-pass transmembrane protein with its gene located at chromosome 8q22 , the abnormalities of which have been identified in several tumor types. MTDH is overexpressed in a number of malignancies, such as breast cancer, malignant glioma, and neuroblastoma , and its overexpression is associated with poor clinical outcome. MTDH plays an important role in the regulation of carcinogenesis and tumor progression. This antibody got two bands about 70 kDa and 80 kDa in western blotting, possibly due to posttranslational modification. This antibody is specific to AEG-1/MTDH.
-
References
- Yu C, Liu Y, Tan H. Metadherin regulates metastasis of squamous cell carcinoma of the head and neck via AKT signalling pathway-mediated epithelial-mesenchymal transition. Cancer letters. 343(2):258-67. 2014.
- Yang G, Zhang L, Lin S. AEG-1 is associated with tumor progression in nonmuscle-invasive bladder cancer. Medical oncology (Northwood, London, England). 31(6):986. 2014.
- Zhu GC, Yu CY, She L. Metadherin regulation of vascular endothelial growth factor expression is dependent upon the PI3K/Akt pathway in squamous cell carcinoma of the head and neck. Medicine. 94(6):e502. 2015.
- Yan JJ, Zhang YN, Liao JZ. MiR-497 suppresses angiogenesis and metastasis of hepatocellular carcinoma by inhibiting VEGFA and AEG-1. Oncotarget. 6(30):29527-42. 2015.
- Tong L, Wang C, Hu X. Correlated overexpression of metadherin and SND1 in glioma cells. Biological chemistry. 397(1):57-65. 2016.
- Song H, Li C, Li R, Geng J. Prognostic significance of AEG-1 expression in colorectal carcinoma. International journal of colorectal disease. 25(10):1201-9. 2010.
- there was a problem with your PMID, try again.
- Li C, Li R, Song H. Significance of AEG-1 expression in correlation with VEGF, microvessel density and clinicopathological characteristics in triple-negative breast cancer. Journal of surgical oncology. 103(2):184-92. 2011.
Related Products / Services
Please note: All products are "FOR RESEARCH USE ONLY AND ARE NOT INTENDED FOR DIAGNOSTIC OR THERAPEUTIC USE"
